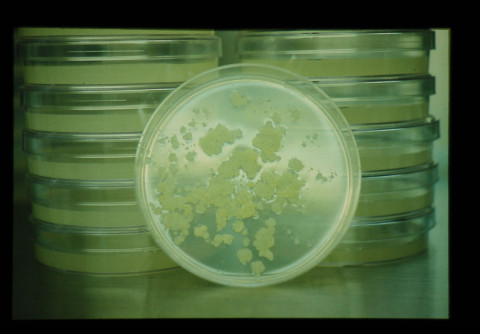

熱帯・亜熱帯有用作物の育種

有用作物の育種の基礎研究はこれまで主として作物育種研究室が実施してきているが、牧草については旧作物導入馴化研究室が担当してきた。なお、平成元年度からは牧草は作物育種研究室、パインアップルは熱帯果樹研究室でそれぞれ実施することになった。研究対象作物には当初サトウキビとパインアップルを選定し、その遺伝資源の探索導入が行われ、サトウキビ200余種、パインアップル100余種の品種・系統を収集した。サトウキビについては、導入品種の生理・生態的特性を解明するとともに、出穂制御、高糖多収に関与する遺伝形質の推定、生育特性、特に乾物増加に関与する環境要因及びN肥料の影響、耐風性の解析が進められた。さらに、サトウキビの育種事業遂行上不可欠な多様な遺伝子型の作出のための基礎技術としてのプロトプラストの作出に成功し、現在、その分裂カルスから根の発生を認めるに至っている。
パインアップルについては、収集した品種・系統の諸形質を解析し、従来のカイエン、クィーン、レッドスパニッシュの3群に加えて、ブランコ、アマレロ、その他として台湾交配系統の6群に分類した。この研究は品種の系統関係の解明や交配組合せの選定に有益な知見を与えている。さらに、植物調節剤利用による増殖効率の向上、栄養系の組織培養による長期保存などの技術を開発している。最近では生食用優良品種の選定が重要課題となり、クィーン群、ブランコ群に有望な品種が見出されている。また、鑑賞用として有望な系統も見出されており、特性調査が進められている。このほか前述のギニアグラスのアポミクシス育種法の研究についても実施中である。
パインアップルについては、収集した品種・系統の諸形質を解析し、従来のカイエン、クィーン、レッドスパニッシュの3群に加えて、ブランコ、アマレロ、その他として台湾交配系統の6群に分類した。この研究は品種の系統関係の解明や交配組合せの選定に有益な知見を与えている。さらに、植物調節剤利用による増殖効率の向上、栄養系の組織培養による長期保存などの技術を開発している。最近では生食用優良品種の選定が重要課題となり、クィーン群、ブランコ群に有望な品種が見出されている。また、鑑賞用として有望な系統も見出されており、特性調査が進められている。このほか前述のギニアグラスのアポミクシス育種法の研究についても実施中である。
課題No.
p0053
事業実施:開始年
1972
事業実施:終了年
1993
対象国